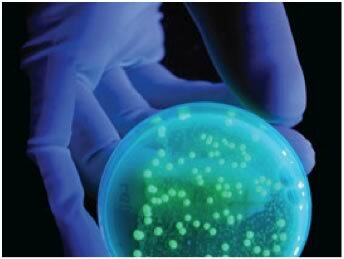

![]()
(c)iStockphoto.com/StephenSewell
紫外線技術は、潅水のために排水溝の水を処理することのできる潜在性を備えている。
食用作物のための灌水の有用性は、特に、ベリー類と野菜を育てる農家にとって重要である。
しかし、今の技術を使うことが出来るようになる前は、つまり、潅水とそれを処理する紫外線(UV)システムは、監査機関の基準に合わなければならなかった。
実際、水需要と水安全性の関係は常に、手頃な費用での処理解決案を含むべき繊細なバランスを必要とすると、リン・ラシュック(ブリティッシュ・コロンビア(BC)農業委員会会議員)は指摘する。
BCの農業証明書は、全く印象的である。
2006年のカナダ国勢調査の統計によると、この地域は農場収益では27億ドル、農村地帯の成長率は9.6%(これは国家平均を0.1%以上上回る)を記録した。
この局面の中で、農業環境パートナーシップ・イニシアティブ(Agriculture Environment Partnership Initiative)が野菜マーケティングコミッションに対して1年に18,000ドルの研究補助金を与えたことは、意義深い。同コミッションは、これにより農業潅水のために排水溝の水を処理する際のUV技術の効果を評価することが可能になった。
より詳しく言うと、コミッションは、灌水中の微生物病原菌の濃度を減らすためにUV効果を実証することを望んでいる。そしてそれがこの地方(BC)の水質ガイドラインに適応するようにしようとしている。
2002年に、BC の水・大気・土地保全省は、サリー(BC)の周辺で、水をテストした。
結果は大腸菌濃度がニカメックリ・リバーでプロヴィンシャル灌水-品質ガイドラインを上回ることを示した。その水は、クロバーデール区域の野菜とベリー類のための灌水供給として用いられているものなのだ。
アボッツフォード(BC)の農業と土地省のステファニー・タムによると、それらの大腸菌濃度は、潜在的に人間の健康障害を生み出すかもしれないという。
マッキ・プレリーを含むメインランドの下流にあるいくつかの区域は、地表水が一番の潅水供給源となる場所であるが、そこの予備試料水も同種の結果を示した。農業食物水産省によると、BCの地表水供給の多くには、人間の健康に危険を及ぼす恐れのある病原菌が含まれている。農業排水溝はしばしば潅水と作物洗浄廃水を供給するが、しかし、これらの供給は特に低品質の傾向がある。
もちろん、すべての地表面の水源は、腐敗性物質のある現場、家畜糞尿と乳製品加工工場、ゴミと野生生物などからの病原菌で汚染される可能性がある。
潅水(または表層水)は多くの供給源から汚染にさらされているので、識別とモニタリングの複雑で高価な水性環境の微生物をのせた、広範囲で多様なリストがあると、ラシュックは言う。
糞便に含まれる大腸菌群は、一般に、全体的な糞便汚染に対する簡単に検知可能な指標微生物として使われるが、これは、この種の大腸菌群は他の病原菌が存在する時にのみ存在するので、検査を単純化するために指標としているのである。つまり、汚水中にこの菌が見つかればここには他の病原菌も存在するということになる。この方法は、関心のある病原菌を探し出すために、間違った試験と助力を重ねずに識別するのに役立っている。





